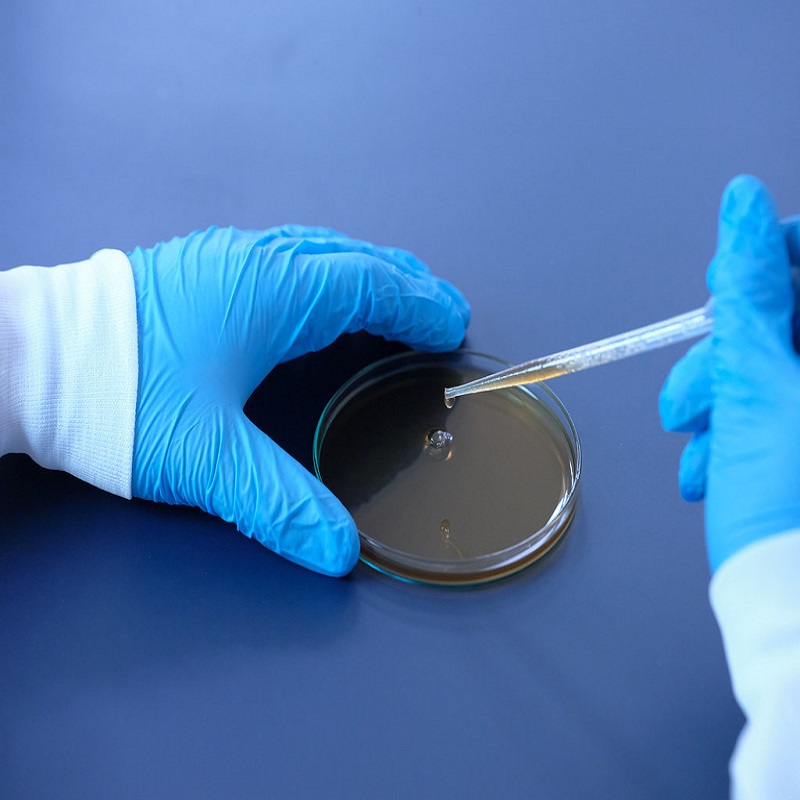

Last farewell to Ram Vilas Paswan, President Kovind and PM Modi pay tribute
- Friday | 9th October, 2020
Brainstorming second phase candidates in LJP after fielding 42 candidates
- Friday | 9th October, 2020
Former PM Manmohan Singh: Ram Vilas Paswan was a mass leader with considerable popularity
- Friday | 9th October, 2020